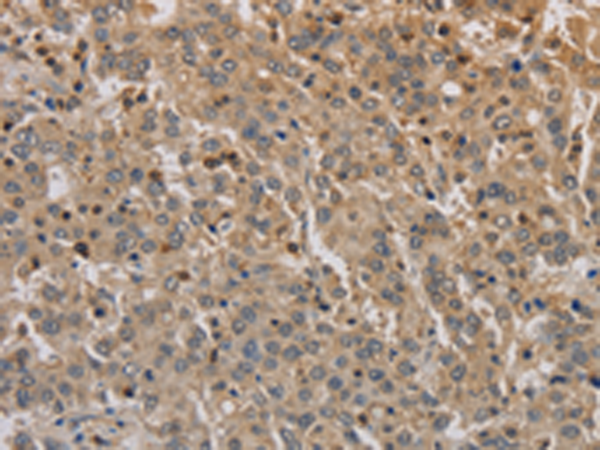
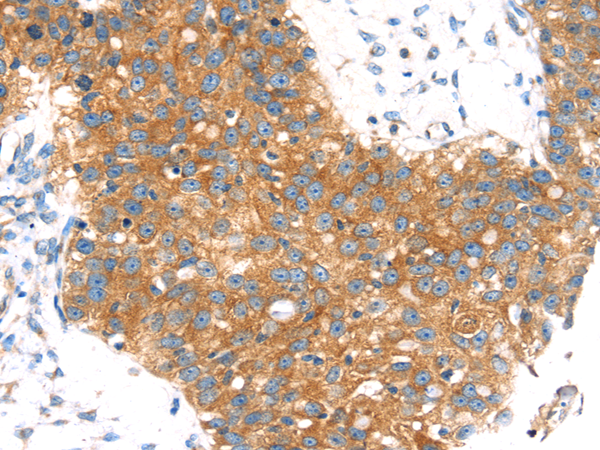
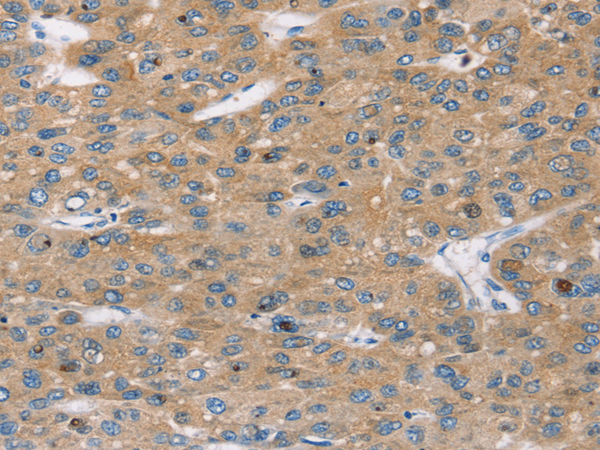

-
分类: 科研抗体货号: P10652别名:应用: WB,IHC反应种属: Human, Mouse
-
分类: 科研抗体货号: P10626别名: CREST; LP2261应用: IHC反应种属: Human, Mouse, Rat
-
分类: 科研抗体货号: P10649别名: BETA3AR应用: IHC反应种属: Human
-
分类: 科研抗体货号: P10625别名: AN3; MC7; DIPB; HSA249128应用: WB,IHC反应种属: Human, Mouse, Rat
-
分类: 科研抗体货号: P10648别名: BAR, B2AR, ADRBR, ADRB2R, BETA2AR应用: WB,IHC反应种属: Human, Mouse
-
分类: 科研抗体货号: P10624别名: OOMA1; PLEIAD; C5orf25应用: IHC反应种属: Human
-
分类: 科研抗体货号: P10646别名: C10orf22应用: WB,IHC反应种属: Human, Mouse
-
分类: 科研抗体货号: P10668别名: H9, ARH9, ARHC, RHOH9应用: WB反应种属: Human, Mouse
-
分类: 科研抗体货号: P10645别名: AM2; dJ579N16.4应用: IHC反应种属: Human, Mouse, Rat
-
分类: 科研抗体货号: P10666别名: ADTG; CLAPG1应用: IHC反应种属: Human, Mouse

鄂公网安备42018502007531号
鄂公网安备42018502007531号

